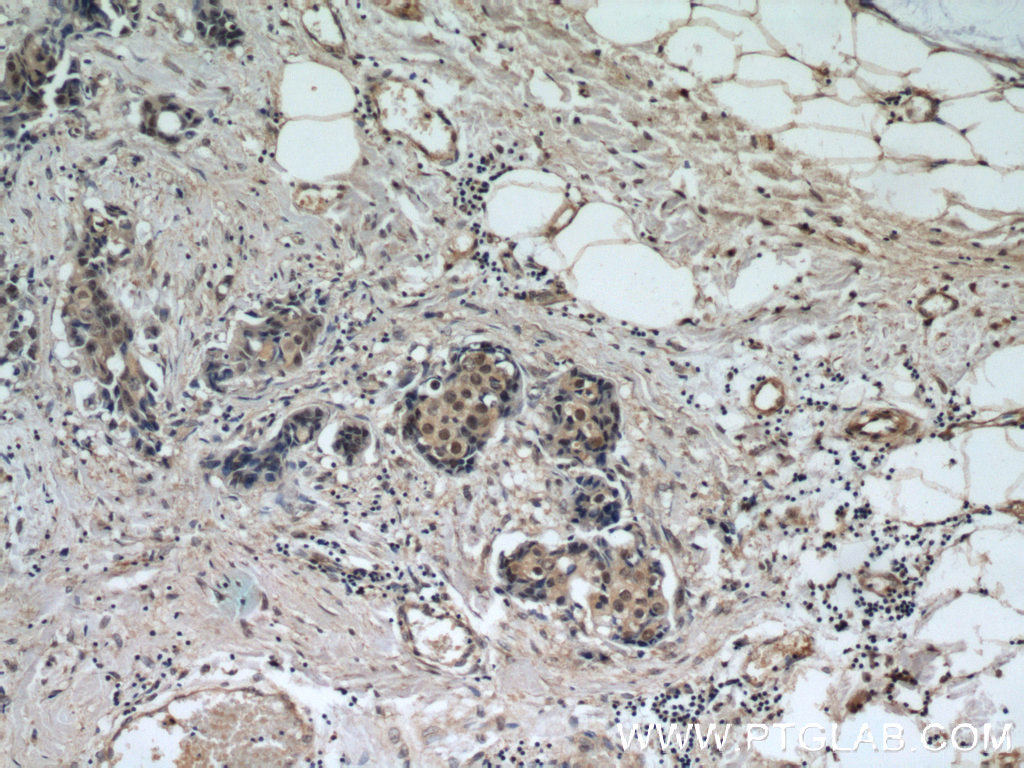

验证数据展示
经过测试的应用
| Positive WB detected in | K-562 cells, COLO 320 cells, HeLa cells, human heart tissue, mouse brain tissue, rat brain tissue |
| Positive IP detected in | HeLa cells, mouse brain tissue |
| Positive IHC detected in | human breast cancer tissue, human brain tissue Note: suggested antigen retrieval with TE buffer pH 9.0; (*) Alternatively, antigen retrieval may be performed with citrate buffer pH 6.0 |
| Positive IF-P detected in | mouse testis tissue |
| Positive IF/ICC detected in | HeLa cells |
推荐稀释比
| 应用 | 推荐稀释比 |
|---|---|
| Western Blot (WB) | WB : 1:1000-1:6000 |
| Immunoprecipitation (IP) | IP : 0.5-4.0 ug for 1.0-3.0 mg of total protein lysate |
| Immunohistochemistry (IHC) | IHC : 1:20-1:200 |
| Immunofluorescence (IF)-P | IF-P : 1:50-1:500 |
| Immunofluorescence (IF)/ICC | IF/ICC : 1:400-1:1600 |
| It is recommended that this reagent should be titrated in each testing system to obtain optimal results. | |
| Sample-dependent, Check data in validation data gallery. | |
产品信息
12439-1-AP targets CREST in WB, IHC, IF/ICC, IF-P, IP, CoIP, ChIP, ELISA applications and shows reactivity with human, mouse, rat samples.
| 经测试应用 | WB, IHC, IF/ICC, IF-P, IP, ELISA Application Description |
| 文献引用应用 | WB, IHC, IF, CoIP, ChIP |
| 经测试反应性 | human, mouse, rat |
| 文献引用反应性 | human, mouse, rat, drosophila |
| 免疫原 |
CatNo: Ag3119 Product name: Recombinant human CREST protein Source: e coli.-derived, PGEX-4T Tag: GST Domain: 47-396 aa of BC034494 Sequence: CTQYQQILHRNLVYLATIADSNQNMQSLLPAPPTQNMNLGPGALTQSGSSQGLHSQGSLSDAISTGLPPSSLLQGQIGNGPSHVSMQQTAPNTLPTTSMSISGPGYSHAGPASQGVPMQGQGTIGNYVSRTNINMQSNPVSMIQQQAATSHYSSAQGGSQHYQGQSSIAMMGQGSQGSSMMGQRPMAPYRPSQQGSSQQYLGQEEYYGEQYSHSQGAAEPMGQQYYPDGHGDYAYQQSSYTEQSYDRSFEESTQHYYEGGNSQYSQQQAGYQQGAAQQQTYSQQQYPSQQSYPGQQQGYGSAQGAPSQYPGYQQGQGQQYGSYRAPQTAPSAQQQRPYGYEQGQYGNYQQ 种属同源性预测 |
| 宿主/亚型 | Rabbit / IgG |
| 抗体类别 | Polyclonal |
| 产品类型 | Antibody |
| 全称 | synovial sarcoma translocation gene on chromosome 18-like 1 |
| 别名 | SS18L1, Calcium-responsive transactivator, KIAA0693, LP2261, SS18 like protein 1 |
| 计算分子量 | 396 aa, 43 kDa |
| 观测分子量 | 55 kDa |
| GenBank蛋白编号 | BC034494 |
| 基因名称 | CREST |
| Gene ID (NCBI) | 26039 |
| RRID | AB_2302517 |
| 偶联类型 | Unconjugated |
| 形式 | Liquid |
| 纯化方式 | Antigen affinity purification |
| UNIPROT ID | O75177 |
| 储存缓冲液 | PBS with 0.02% sodium azide and 50% glycerol, pH 7.3. |
| 储存条件 | Store at -20°C. Stable for one year after shipment. Aliquoting is unnecessary for -20oC storage. |
背景介绍
CREST, also named as SS18-like 1(SS18L1) is a transcriptional activator that is required for calcium-dependent dendritic growth and branching in cortical neurons. It's also a nuclear protein interacts with CREB-binding protein and expressed in the developing brain. It helps regulate neuronal morphogenesis in calcuim-dependent manner. The N-terminal domain of SS18L1 is required for suppressing transactivation in the basal state, while the C-terminal domain is required for calcium-induced transactivation. It's part of the CREST-BRG1 complex, a multiprotein complex that regulates promoter activation by orchestrating a calcium-dependent release of a repressor complex and a recruitment of an activator complex. This complex also binds to the NR2B promoter, and activity-dependent induction of NR2B expression involves a release of HDAC1 and recruitment of CREBBP. The calculated molecular weight of CREST is about 43 kDa, but the modified of CREST protein is 55 kDa (PMID: 25888396). CREST exists some isoforms with calulated MV 43, 40, 33 and 29 kDa.
实验方案
| Product Specific Protocols | |
|---|---|
| IF protocol for CREST antibody 12439-1-AP | Download protocol |
| IHC protocol for CREST antibody 12439-1-AP | Download protocol |
| IP protocol for CREST antibody 12439-1-AP | Download protocol |
| WB protocol for CREST antibody 12439-1-AP | Download protocol |
| Standard Protocols | |
|---|---|
| Click here to view our Standard Protocols |
发表文章
| Species | Application | Title |
|---|---|---|
Nat Commun Cep57 is a Mis12-interacting kinetochore protein involved in kinetochore targeting of Mad1-Mad2. | ||
J Neurosci Kinetic Analysis of npBAF to nBAF Switching Reveals Exchange of SS18 with CREST and Integration with Neural Developmental Pathways. | ||
Cancers (Basel) Global Chromatin Changes Resulting from Single-Gene Inactivation-The Role of SMARCB1 in Malignant Rhabdoid Tumor. | ||
J Neurosci CREST in the Nucleus Accumbens Core Regulates Cocaine Conditioned Place Preference, Cocaine-Seeking Behavior, and Synaptic Plasticity. | ||
PLoS Genet Calcium-responsive transactivator (CREST) toxicity is rescued by loss of PBP1/ATXN2 function in a novel yeast proteinopathy model and in transgenic flies. |